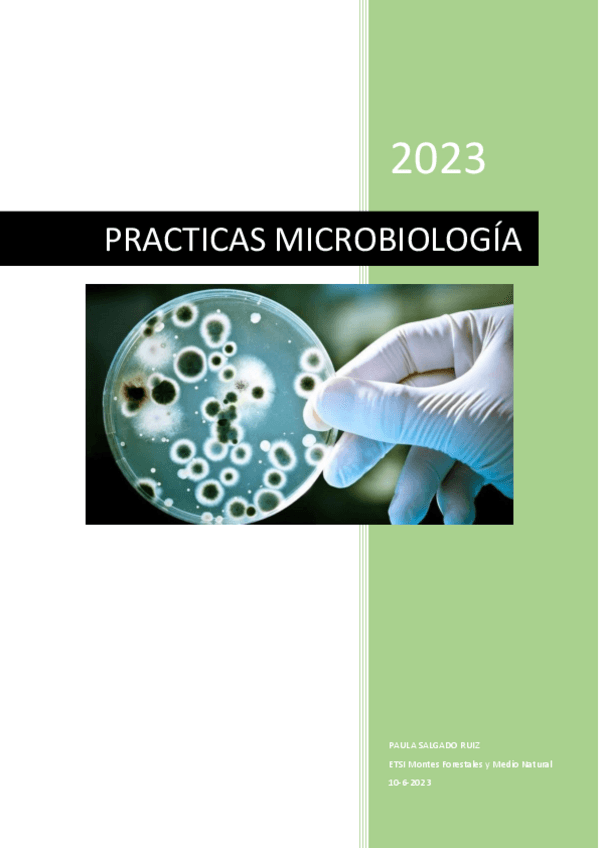

@gaambita
71 Publicaciones
1.06k Interacciones
0 Seguidores
0 Siguiendo
Lista de publicaciones de gaambita
He publicado nuevos examenes de 2º Recursos Hídricos y Gestión de Cuencas: examen-recursos-hidricos-20242025.pdf
He publicado nuevos examenes de 3º Planificación Física y Paisaje: EXAMEN-PLANIFICACION-FISICA-23-junio-2020-2.pdf
He publicado nuevos examenes de 2º Informática y Modelización: segundo-parcial-2020-maple.pdf
He publicado nuevos apuntes de 2º Biometría: FormularioparteJoaquin.pdf
He publicado nuevos apuntes de 2º Geomática Aplicada: SALGADORUIZpaulaP4Y5.pdf
He publicado nuevos apuntes de 2º Geomática Aplicada: 02-Examen-geomatica.pdf
He publicado nuevos apuntes de 2º Geomática Aplicada: cuadernogeomaticaSalgadoPaula.pdf
He publicado nuevos apuntes de 2º Microbiología Aplicada: TEMA-13-LA-BIORREMEDIACION.pdf
He publicado nuevos apuntes de 2º Microbiología Aplicada: TEMA-12-LAS-AGUAS-RESIDUALES.pdf
He publicado nuevos apuntes de 2º Microbiología Aplicada: TEMA-11-CONTROL-BIOLOGICO-DE-PLAGAS-Y-ENFERMEDADES-FORESTALES.pdf
He publicado nuevos apuntes de 2º Microbiología Aplicada: TEMA-10-BIODEGRADACION-DE-COMPUESTOS-AROMATICOS.pdf
He publicado nuevos apuntes de 2º Microbiología Aplicada: TEMA-9-MICROORGANISMOS-DEL-SUELO.pdf
He publicado nuevos apuntes de 2º Microbiología Aplicada: TEMA-3-LAS-BACTERIAS.pdf
He publicado nuevos apuntes de 2º Microbiología Aplicada: TEMA-2-LOS-VIRUS.pdf
He publicado nuevos examenes de 3º Gestión Agraria: EXAMEN-PSACICULTURA.pdf
He publicado nuevos examenes de 3º Gestión Agraria: TEST-SELVICULTURA.pdf
He publicado nuevos apuntes de 3º Gestión Agraria: ejercicios-caza-Ramon.pdf
He publicado nuevos apuntes de 3º Gestión Agraria: formulario-ejercicios-caza.pdf
He publicado nuevos examenes de 2º Informática y Modelización: examen-MAPLE-DIC2023.pdf